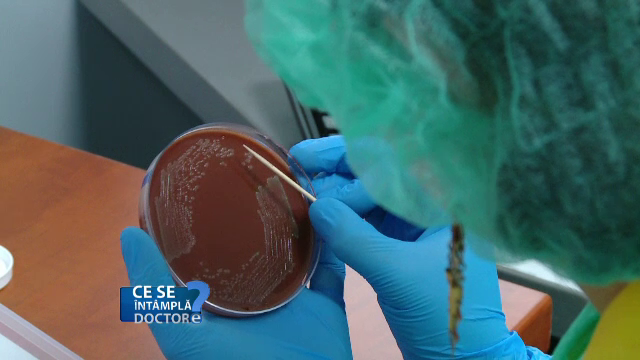
infectie

"Am luat medicamente fara sa tin cont ca sunt insarcinata". Dupa cat timp de la formarea embrionului poate deveni o problema
"Am luat medicamente fara sa tin cont ca sunt insarcinata". O astfel de informatie trebuie comunicata imediat medicului. Pe de alta parte, orice pastila poate afecta embrionul abia la 24 de ore de la formare.
Ceea ce trebuie sa stiti este ca embrionul se formeaza in trompele uterine si apoi migreza in uter. Legatura lui cu mama se produce la 24 de ore de la fecundatie, iar in acest timp nu-l afecteaza medicatia.

Dupa fiecare contact intim, 300 de milioane de spermatozoizi inainteaza spre uter. Majoritatea moare pe drum. In uter, spre exemplu, sunt atacati de celulele sistemului imunitar al femeii. Supravietuitorii se muta spre trompa uterina, unde vor intalni ovulul. Pentru ca viata sa apara, trompele uterine trebuie sa fie in stare perfecta!
Dr. Ruxandra Dumitrescu, medic primar infertilitate: "Orice intrerupere de sarcina poate duce la un reflux de sange pe trompe, care sa duca la obstruarea lor, orice infectie genitala cu ureaplasma, mycoplasma si chlamydia poate sa duca la o umplere cu lichid. Impiedica formarea oului la nivel lor."
De aceea infectiile au nevoie sa fie tratate la timp. Cele mai multe nu dau simptome. E util asadar un examen bacteriologic anual. Odata format in trompele uterine, embrionul va migra spre uter.
Dr. Ruxandra Dumitrescu, medic primar infertilitate: "Pana atunci embrionul se hraneste singur din interior si este independent, nu depinde de organismul gazda. De aceea medicatia luata in timp ce s-a fecundat nu-l va afecta. Femeile sunt speriate ca au luat in acel moment medicamente care nu se iau in sarcina, dar legatura lui cu mama se produce cam la 24 de ore de la fecundatie."

Dar daca ati lua un medicament fara sa fi stiut de sarcina trebuie sa ii spuneti imediat medicului. Acesta va aprecia posibila toxicitate asupra embrionului. De sarcina veti afla cel mai devreme la 4-5 saptamani de la prinderea ei. In acest interval sistemul nervos al viitorului copil, dar si inima se formeaza deja.
Dr. Vythoulkas Andreas, medic specialist ginecolog: "Orice vi se pare ciudat, puneti mana si ma sunati sau veniti sa va vad. Niciodata, chiar niciodata nu trebuie sa luam tratament ca am auzit de la cineva pentru ca exista foarte mare riscul sa gresim, iar in timpul sarcinii ar fi bine sa nu gresim!"
Doar unele clase de medicamente au fost testate pe gravide si doar despre acestea se cunoaste ca nu au efecte toxice asupra fatului.
Etichete: aparat genital, csid, embrion, infectari, medicamente, sarcina, uter,
Dată publicare:























